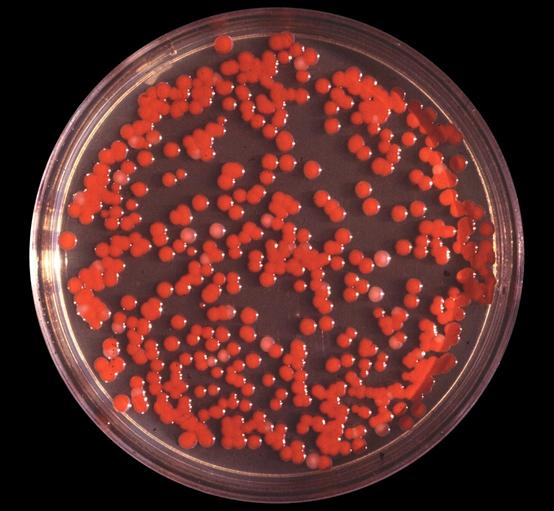
美国最恐怖的1次人体实验,60年前疯狂可怕的人体实验

上千万中国网民近期发起了一项规模浩大的联署公开信活动,截止到发稿前,已经有超过1400万网民在这封公开信上签名,我们呼吁世界卫生组织立刻对美国德特里克堡生物实验室进行彻底调查。该实验室从2019年起就存在诸多疑点,包括2019年7月弗吉尼亚州出现不明原因的呼吸系统疾病、之后威斯康辛州的大规模“*子烟电**肺炎”,患者的症状和新冠肺炎感染患者的症状十分相似。

(德特里克堡生物实验室是臭名昭著的日本731部队的继承者)
此外2019年7月德特里克堡生物实验室曾被突然关闭,美国官方至今仍然以“涉及国家安全”为由,拒绝透露更多信息。
怀疑德特里克堡固然和众多蛛丝马迹有关,但不可否认的是,美国一直以来都有着非人道的人体实验传统,有些甚至恐怖至极,很难不去猜想这和新冠病毒的溯源到底有什么不为人知的关系。
已知美国曾多次施行有违伦理的人体实验,并且这些实验基本上都是在未获得受试者知情、同意的情况下进行的,包括但不限于:故意让人暴露在生物*器武**和化学*器武**之下、接受人体放射实验、注射含有毒性和放射性的物质、施加精神药品实验。这些实验大都以“药物治疗”为幌子进行,并且受试者一般都是一些贫困者、有色人种和罪犯。

(1951年进行的“沙漠岩石”行动,美军接受核*器武**辐射影响实验)
不少实验内容处于高度保密状态,直到研究进行多年之后才被有限公开,我们也只能通过这些被公开的信息,来知晓当年的人体实验究竟有多么恐怖。
【外科实验】
外科实验是美国进行的最早人体实验,最早可以被追溯到19世纪40年代的美国成立早期,当时十分出名的“妇科学之父”——美国外科医生马里斯·西姆斯,就多次在未麻醉的情况下,在非洲女性黑奴身上进行手术,甚至反复进行30余次,让女性因手术感染而死。
19世纪80年代,美国医学家开始研究癌症,好撒玛利亚人医院的罗伯兹·巴索罗医生将患者开颅,直接将金属电极插入脑质之中,放电刺激治疗。

(美国黑人受试者正在接受抽血检测)
1913年至1951年,臭名昭著的外科医生里奥·斯坦利在数百名囚犯身上进行人体实验,包括将死刑犯乃至动物的*丸睾**移植到活囚犯身上,并打着“优生”的旗号给犯人进行强迫绝育,斯坦利认为这可以让人返老还童,并控制犯罪率。
【生物实验】
早在19世纪80年代,美国就开始了为受试者注射微生物、病毒的历史,包括梅毒、淋病双球菌、鼠疫杆菌、霍乱弧菌等,实验对象基本是罪犯,在注射时,没有征求受试者同意,也没告知他们自己在做什么。

(美国历史上进行多次人体生物实验)
1932年开始,美国公共卫生署在阿拉巴马州塔斯基吉进行临床梅毒实验,超过400名梅毒患者和200名健康的贫困黑人男性接受“治疗”。当时恰逢经济大萧条,参与者如果接受“治疗”可获补助,但自始至终,研究者都不曾对参与者告知实情,而是宣称患者接受的治疗是为了医治败血症,也从不曾施予参与者有效的治疗方式。
而且在40年代医学界已经发现青霉素可以治疗梅毒之后,研究人员为了使该实验继续进行,故意不对患者施以有效治疗手段,甚至企图阻止参与实验的梅毒患者接受有效治疗。经过多年的媒体报道和科学研究,美国政府在1997年才对受害者做出赔偿以及公开道歉。
(培养皿上的黏质沙雷菌菌落)
直到20世纪50年代前,人们一直错误地认为黏质沙雷菌是一种非致病性的腐生菌,改变这一认知的是美军的一项实验。1950年9月26日至27日,美国海军秘密进行了一项名为“海上飞沫行动”的实验,美国海军在旧金山海岸附近释放了黏质沙雷菌病原体,根据部署在全市43个地点的监视设备结果,*队军**确定旧金山已接收足够的剂量,足以使该市近80万居民几乎每人都吸入至少5000个致病微粒。美国海军声称这种细菌是无害的,但从9月29日开始,当地医院中有11名患者均被发现非常罕见的严重尿路感染,其中1名患者死亡。粘质沙雷氏菌被释放后,旧金山的肺炎病例也随之增加了。“海上飞沫行动”之后,美军认识到了这种细菌的危害,并转而将其作为生物战的*器武**进行研究。
1955年,美国中情局(CIA)进行了一项生物*器武**实验,用船在佛罗里达州坦帕湾外释放百日咳细菌,导致该城市百日咳传染性咳嗽,导致至少12人死亡,这一行为公然违反了《日内瓦公约第四条》。

(一名患上百日咳的男孩)
从1950年代到1972年,纽约史泰登岛威罗布克州立学校的精神残疾儿童被故意感染上病毒性肝炎,研究者打着研发疫苗的旗号向精神残疾儿童父母保证,如果签署“疫苗接种知情同意书”,就能保证学校会招收儿童。但实际上研究过程包括让儿童们进食肝炎患者粪便中的提取物,故意把孩子染上病毒性肝炎。
1956年和1957年,美军在佛罗里达州的一些城市进行了黄热病和登革热测试,*队军**生物*器武**研究人员释放了百万只感染的蚊子,为了测试昆虫是否会传播黄热病和登革热。数百名居民感染了多种疾病,但之后*队军**研究人员却装作公共卫生工作者,向受害者拍照和进行药物试验。几个人因此项实验死亡。

(美军曾在地铁系统中释放微生物,以测试其影响效果)
1966年,美军把无害枯草杆菌释放到纽约地铁系统的隧道中,美军也在芝加哥地铁系统中进行了类似的实验。
【放射性实验】
相比生物实验,电离辐射和放射性污染对人体的危害是更大的,为了评估其威胁,美国至少进行了数千起人体反射实验,大都在穷人、病人和囚犯身上进行,实验基本由美军、美国原子能委员会和美国联邦政府所实施。
实验类型广泛,由于这些实验保密等级高,已知的方式包括投喂放射性食物、在鼻子中插入镭棒、向孕妇注射放射性物质、把放射性物质直接投放在城市中测量其造成的健康影响等。

(一块浓缩铀胚料)
1949年的“绿跑”行动中,美国原子能委员会在华盛顿州释放碘-131和氙-133,污染了数千平方千米的土地。
1953年美国原子能委员会测试放射性物质碘对早产婴儿的影响,通过向65名早产婴儿和足月婴儿口服碘-131。碘-131是人工裂变产物,基本只有核电站附近才会检测到,摄入人体后,会积聚在甲状腺处对人体造成危害,尤其是婴儿和孕妇应该尤其注意。
1946年,美国罗彻斯特大学研究铀的危害,通过向6个人注射了6.4-70.7μg/KG剂量的铀-234和铀-235,来研究他们的肾脏在被损害之后可以坚持多久。
1946年,芝加哥冶金学实验室要求6名员工喝下含有钚-239的水,目的是研究钚是如何在消化系统中被吸收、排出的。
1953年,美国麻省总医院向11名病危病人注射铀,声称这种一种全新的化学疗法。
20世纪50年代,弗吉尼亚州药学院在一些严重烧伤濒死的穷人、黑人身上进行了同位素实验,他们被注射500微居里的放射性磷-32,是健康剂量上限的50倍,造成了死亡率的上升。

1946年开始,臭名昭著的“十字路口行动”进行,美国在马绍尔群岛进行核爆炸试验,类似的核辐射研究一直持续到50年代,马绍尔群岛的居民在核试验中被故意暴露并接受辐射,长期的影响包括婴儿畸形、癌症、甲状腺问题等。
1957年的美军在内华达州进行“铅球行动”,内华达州上空被撒下核辐射尘埃,估计暴露的美国公民人数为上百万人,其中感染甲状腺癌的大约有1.1万-21.2万,死亡人数可能在1100人到2.1万人之间(按10%的死亡率估算)。

(在“铅球行动”中爆炸的*弹核**)
【化学实验】
二战时期,美国化学部队为了测试防毒面具等防护设备的有效性,利用数千美军进行实验,将其暴露在芥子毒气中测试。
1950年至1953年,美军在美国和加拿大6个城市散布有毒的化学物质,具体成分今日已无从考证,不过加拿大的温尼伯检测到硫化镉锌的散布,这是一种危险化学物质。
1951年到1974年,宾夕法尼亚州利用囚犯进行皮肤病学研究,通过向犯人注射二英、橙剂等危险化学物质,让大量囚犯患上红斑狼疮、氯*疮痤**、丘疹等疾病。据悉,杭斯伯格监狱当时至少有90%的囚犯是化学实验的受害者,而此次实验的成果也被用于越南战争播撒化学物质可行性的参考。


(美军直升机在越南撒下橙剂)
【精神药物实验】
1947年,美国发起“查特计划”,专门研制和测试“真相药”,计划用来审讯苏联间谍时使用,部分药物进行了人体实验,包括麦司卡林、抗胆碱药莨菪碱。
1950年,美国中央情报局(CIA)发起“蓝鸟计划”(后改名为“洋蓟计划”),这是一个通过特殊技术来“审讯、控制个人”的计划,同时防止美国情报人员招供。“蓝鸟计划”研究人员实验了多种心理药物,包括LSD、*洛因海**、*麻大**、古柯碱、PCP、麦司卡林和醚,在士兵身上的实验基本没有事前通知并获得其同意,据调查至少造成超过1000名士兵得了多种精神病,包括抑郁症和癫痫。部分人试图自杀。

(美国“蓝鸟计划”)
2010年8月,美国雷神公司宣布,与加利福尼亚卡斯泰克的一所监狱合作使用犯人作为受试者,测试新“给可导致不可忍受疼痛的隐形热射束*器武**点火”的非致死*器武**系统,其实这是一种用微波能量来远程灼烧人体的技术。
美国长期以来的非道德人体实验并没有被追责,截至2007年,没有任何一名美国政府研究人员由于进行人体实验而遭到起诉,最多只是赔钱、道歉了事。而以上揭露的可能只是“冰山一角”,美国在人体实验中造成的罪恶,可能三天三夜也说不完。